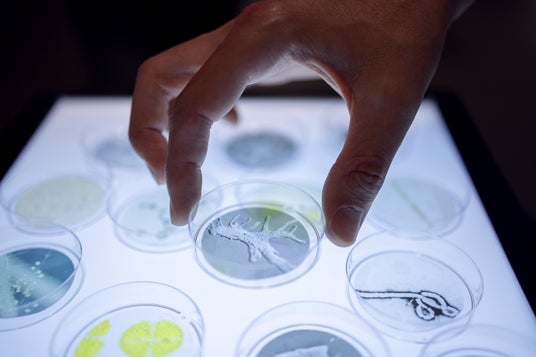

科学と芸術の丘実行委員会
大使館との新たな連携、世界的なメディアアートの文化機関・アルスエレクトロニカとの共同キュレーションによる参加アーティスト&プログラムを発表

10月24日(金)~26日(日)に開催する科学、芸術、自然をつなぐ国際フェスティバル「科学と芸術の丘」のメイン会場・戸定邸、松雲亭、戸定が丘歴史公園のプログラムが決定しました。
今年のテーマ「Delta of Creativity -創造のΔ-」を軸に、エキシビジョン、ワークショップ、トークを実施します。
公式サイト:https://science-art-matsudo.net/
#エキシビジョン
戸定邸・松雲亭にて、大使館の協力による企画や、アルスエレクトロニカとともにキュレーションした作品展示を行います。
【在日スイス大使館・科学技術部協力】
「INVISIBLES:微生物たちの隠された世界」巡回展及びサテライト展示
(C) Musee de la main UNIL-CHUV
在日スイス大使館・科学技術部の協力のもと、スイス国立研究拠点(NCCRマイクロバイオーム)とスイス・ローザンヌに所在するミュゼ・ド・ラ・マンが共同で企画した展覧会「INVISIBLES:微生物たちの隠された世界」が、巡回展およびサテライト展示としてご覧いただけます。
この展覧会では、私たちの生活と密接に関わる微生物という、魅力的でありながらあまり知られていない世界を紹介します。微生物は遍在しながらも目に見えず、コミュニティ(マイクロバイオーム)を形成し、健康や環境において極めて重要な役割を担っています。地球上の生命の起源である微生物は、あらゆる生態系の均衡を支える存在でもあります。土壌から海、空気から植物、そして人間の体内に至るまで――展覧会は、来場者をその隠された世界を探訪する旅へと誘います。

NCCR Microbiomes
自然界や健康のあらゆる側面における微生物群集の役割をより深く理解することを目的とした、スイス全土に広がる研究ネットワークです。スイス全土から集まった25の研究チームで構成されており、ローザンヌ大学、チューリッヒ工科大学、ローザンヌ連邦工科大学、チューリッヒ大学、ベルン大学、ローザンヌ大学病院が参加し、人間の感染症、動物の腸内および植物のマイクロバイオーム、ゲノミクスおよび計算生物学、応用・環境微生物学、微生物生態学および進化の分野で、国際的に高く評価される専門家を擁しています。2020年に設立されたNCCRマイクロバイオームは、スイス国立科学財団の支援を受けています。

Musee de la main UNIL-CHUV
科学文化に特化した学際的な施設で、五感を活かしたインタラクティブなテーマ展示を提供。文化的対話と市民参加に力を入れるこの場は、知識と経験が集まり、現代の課題を学際的に考察する機会を来館者に提供します。また、私たちの身体や認識を形づくる活動や知識を探求する場でもあります。没入型かつインタラクティブな展示を通じて、この博物館は好奇心旺盛な人々が集う拠点となっています。

協力:在日スイス大使館・科学技術部
教育・研究・イノベーション分野において、スイスと日本を結ぶ役割を担っています。大学、研究機関、スタートアップ、スタートアップ支援機関、オープンイノベーションの担い手、政府機関などの多様な関係者をつなぎ、特に好奇心や創造性、活力と柔軟な発想を持つ精神に基づいた取り組みを後押しすることで、知識・アイデア・人材の国際的な連携を推進しています。分野や文化の垣根を越えた交流を推進し、スイスの強みを国際的に発信するとともに、革新的な発想や持続的なパートナーシップが生まれる環境を支えています。
【オーストリア文化フォーラム協力】
Imagine Climate Dignity受賞作品
Anca Benera & Arnold Estefan in collaboration with Pavel Brăila《Floral Whispers》

photo: Arnold Estefan
気候変動や土壌汚染などにより、植物の減少と生態系の崩壊が世界各地で深刻化しています。古気候学では、花粉記録といった「自然のアーカイブ」を手がかりに、失われた植生を復元し、未来の気候変動を予測しています。
Anca BeneraとArnold Estefanは、砂漠化の危機にある地域から花粉を採集し、消えゆく植物の記録を残しています。これらのサンプルは将来の研究資料となる可能性を持つと同時に、ミツバチのような花粉媒介者が生態系維持に欠かせない存在であることを示しています。しかし、ミツバチの減少は地球規模での存続にかかわる深刻な脅威です。
歴史上初めて記録された音が蜜蝋の円筒に刻まれたという事実に着想を得て、アーティストたちはその象徴性を今日の環境危機と重ね合わせました。本作では、Pavel Brăilaと協働し、ミツバチの群れ(Apis mellifera)と共に、蜜蝋でできたレコードを制作しました。繊細で、再生できる回数が限られているこのレコードは、針を落とすたびに素材の「記憶」が削られ、やがて静寂へと消えゆきます。

photo: Victoria Tomaschko
Anca Benera & Arnold Estefan
2012年以来、共同で活動。現在はウィーンを拠点に、リサーチを基盤とした学際的な実践を展開しています。歴史的・社会的・地政学的な物語や、それらの背後に潜む権力構造を問い直すことを中心に据えています。近年は環境問題に焦点を当て、軍事活動と環境との関わりを探求。軍事的な想像力が地形、気候、コミュニティをどのように形づくるのかを考察しています。
Pavel Brăila
1990年代半ば以降、映画、映像、インスタレーション、写真、プリント、パフォーマンス、テレビなど、多様なメディアで活動。コンセプチュアルなパフォーマンスと実験映画を通じた、ポストソビエト地域の不安定な経済状況をテーマに活動しています。

協力:オーストリア文化フォーラム
日本におけるオーストリアのアーティストのプラットフォームとして、現代的で革新的、かつ活気に満ちたオーストリアのユニークなイメージを伝える活動を支援しています。日本での相互交流や創造的な出会いの機会を求めているオーストリアのアーティストや研究者のためのハブの役割を果たしています。
【アルスエレクトロニカ・セレクション】
Ars Electronica Award for Digital Humanity / S+T+ARTS Prize Honorary Mention
2025年ダブル受賞作品
Domestic Data Streamers《Synthetic Memories》

「Synthetic Memories」は、生成AIを活用して、失われるリスクのある個人の記憶 を保存することを目指す革新的な研究・デザインプロジェクトです。口頭や文章で語られる記憶を、視覚的で感情豊かなイメージに変換し、特に移住、認知症、文化喪失などの影響を受ける人々に寄り添います。
対話を通して、参加者はAIが生成した画像を確認し、必要に応じて修正を加えながら、自身の記憶の本質を映し出す表現を完成させます。このプロセスにより、深い感情的なつながりが生まれ、記憶の価値を新たな形で共有することが可能になります。
発足以来、本プロジェクトは認知症患者の回想療法、文化遺産の保存、世代間対話などで成果を上げています。また、ワークショップや展示、介護・文化施設との協働を通じて、世界各地のコミュニティに関わり続けています。アート、テクノロジー、社会的イノベーションを融合させ、記憶保存の新たな定義を提示するとともに、文化的つながりの新しい手段を提示するプロジェクトです。

Domestic Data Streamers
バルセロナを拠点とする集団で、ジャーナリスト、研究者、コーダー、アーティスト、データサイエンティスト、建築家、デザイナーなど、多様な分野の専門家で構成。2013年の設立以来、学校や刑務所、美術館などで、映画、インスタレーション、パフォーマンス、展示を通して活動してきました。これまでに45か国以上で活動し、テート・モダン、ザ・バービカン、TED、国連などの著名な機関とも協働。人に寄り添ったデータストーリーテリングや情報倫理に取り組む中で、AIが記憶、アイデンティティ、集団的な物語をどのように変革するかを探求してきました。
【アルスエレクトロニカ・セレクション】
ワコム、TOA、アルスエレクトロニカ・フューチャーラボ《Life Ink Community》

Jochen Manz / Wacom Co., Ltd.
「Life Ink」は、脳と身体における繊細で複雑な創造のプロセスを芸術的に探究するプロジェクトです。バイオセンシング技術と新しいデジタルインクを組み合わせることで、変化し続ける内面の状態を捉え、それを直感的でアクセスしやすい芸術表現へと変換し、目に見えない状態を視覚化します。2025年のアルスエレクトロニカ・フェスティバルでは、オープン・フューチャーラボにて最新のプロトタイプが初公開されます。来場者はバイオセンシング機器を装着し、裸眼立体視3D映像と立体音響を組み合わせた没入型インスタレーション「Life Ink Community」を体験することができます。本プロジェクトは、ワコムとアルスエレクトロニカ・フューチャーラボの長年にわたる共同研究「Future Ink」から発展しました。現在はTOAをサウンドアートのパートナーに迎え、新しいコラボレーションを通じて、一般公開するとともに、プラットフォームとコミュニティのさらなる拡張に取り組んでいます。「Life Ink」は2022年のアルスエレクトロニカ・フェスティバルで初公開され、その後アルスエレクトロニカ・センターの常設展示に加わりました。2025年には「LIFE INKlusive」をはじめとする新たなプロジェクトを生み出す原動力となっています。

Ars Electronica / Magdalena Sick-Leitner
Ars Electronica Futurelab
アーティスティックな研究開発を行うR&Dラボ兼アトリエ。世界中のパートナーと共に、テクノロジーを人間に寄り添う存在へと変え、社会に新たな視点をもたらすことを目指しています。その活動は、インタラクティブなインスタレーションや没入型アート、技術的なソリューション、ワークショップなど多岐にわたります。
ワコム
ペンタブレットや液晶ペンタブレット、デジタルインターフェース・ソリューションのリーディングメーカー。世界中のアーティストやデザイナーが、デジタルアート、映画、ファッション、デザインなどの制作に活用しています。ワコムは「描く」「書く」という行為を追求しつづけ、ペンとインクの体験を超えた新しい表現の世界を切り開いています。
TOA
業務用音響機器のメーカー。1934年に事業をスタートし、現在では空港、鉄道駅、商業施設、学校、工場、スタジアム、コンサートホールなど、世界170か国以上のさまざまな公共空間において、非常時に代表される大切な情報や、ささやかな、あるいは特別な体験をお届けしています。”Smiles for the Public” – 人々が笑顔になれる社会をつくる – を企業価値と定め、人々の暮らしに「安心」「信頼」「感動」を提供することでその姿を実現します。

Nicolas Ferrando, Lois Lammerhuber
協力:アルスエレクトロニカ
オーストリア・リンツに拠点を置く、メディアアートの文化機関。毎年9月にアート・テクノロジー・社会をテーマに行われる「アルスエレクトロニカ・フェスティバル」の他、美術館・科学館としての「アルスエレクトロニカ・センター」、メディアアートの最先端コンペティションである「プリ・アルスエレクトロニカ」、R&D機関である「フューチャーラボ」の4部門を軸に、未来の人と社会を描き続けています。
東京大学DLX Design Lab、東京大学獣医動物行動学研究室、原啓義《都市のネズミ》

Rats in the City(都市のネズミ)は、東京での1年間のネズミの観察に基づいたインタラクティブなインスタレーションと、原啓義の写真作品で構成された展示です。ネズミを害獣としてだけでなく、都市の生態系の一部として捉え、偏見を持たずに見るきっかけを提供します。また、恐怖に基づいたネズミの駆除のあり方に問いを投げかけ、科学的な視点から向き合う新たな方法を考えます。より生態学的にインクルーシブで強靭な都市を促進するため、人と野生動物が共に生きる持続可能な都市の未来を想像します。

東京大学DLX Design Lab
デザインを通じて価値を創造することを目指す国際的なコレクティブ。社会的インパクトの新たな可能性を追求し、デザイン教育を発展させるために、分野を超えたコラボレーションを行っています。
東京大学獣医動物行動学研究室
人と動物のより良い関係を育むために、動物の行動を研究し、コミュニケーションを可能にし、動物の心の理解を深めることを目的としています。
原啓義(写真家)
東京の都会のネズミを記録し、彼らがどのように人間に支配された環境を移動し、適応するかを明らかにする説得力のある視覚的物語を創作しています。
東京大学DLX Design Lab, 東京大学応用昆虫学研究室《Tabemaru》

「Tabemaru」は、昆虫を動力源とする閉鎖型生態系です。内部では、アメリカミズアブ(ブラックソルジャーフライ)の群れが数日で食品廃棄物を豊かな堆肥へと変えます。しかし、これは単なる高速な資源再生ではありません。これは種を超えたデザインの探求でもあります。人と昆虫が、心地よく、そして魅力的に感じられる関わり方をするにはどうすれば良いのでしょうか。もし堆肥化がシンプルで、五感に優しいものであり、日常生活の一部になったらどうでしょうか。「Tabemaru」 は、堆肥化のプロセスを隠すのではなく可視化することで、廃棄物とそれを処理する生き物の見方を問い直します。食べ残しを価値あるものに変え、食品廃棄物や昆虫を私たちの食料循環に欠かせない存在として捉え直すきっかけを提供します。

東京大学DLX Design Lab
先に記載のプロフィールをご参照ください。
東京大学応用昆虫学研究室
1947年に山崎輝男助教授が着任したことに始まり、その後1973年松本義明、1988年池庄司敏明、1993年田付貞洋、2010年石川幸男、2021年霜田政美が教授を務め、松尾隆嗣准教授、星崎杉彦助教の3人体制で現在に至ります。いわゆる昆虫学を担当する研究室として、幅広い分野で研究成果を挙げるとともに、各所で活躍中の人材を多数輩出しています。
三木麻郁×国立病院機構新潟病院臨床研究部医療機器イノベーション研究室 石北直之*《KYOTO STEAM 国際アートコンペティション2022 制作作品「とほく おもほゆ」》

KYOTO STEAM 2022 国際アートコンペティション制作作品
三木麻郁×国立病院機構新潟病院臨床研究部医療機器イノベーション研究室 石北直之*
「とほく おもほゆ」(2022)
撮影:麥生田兵吾
地球規模でのCOVID-19パンデミックを受け、世界中の医療現場で人工呼吸器が足りない窮状を認識した石北直之医師は、3Dプリンタで製造可能な人工呼吸器の設計データを無償公開する。
同じ頃、2011年の東日本大震災以降、しゃぼん玉を吹くという行為を通して追悼を続けていたアーティストの三木麻郁は、自身の吐き出す息が脅威となった唐突な状況に、呼吸という生命の根源的な営みを捉え直す時であることを感じ取っていた。
タイトルは「遠くを自然と思わせる」という意味の古語に由来する。人工呼吸器に取り付けられた笛が、それぞれの存在を鳴らして遠くを思い、共鳴のコミュニティを広げていく。
※本作はアーティストと企業・研究機関が対話を重ねて制作する「KYOTO STEAM 国際アートコンペティション2022」の出品作品として、制作・発表された。

三木麻郁
1987年大阪生まれ。武蔵野美術大学卒業、東京芸術大学大学院修了。自身が遭遇する経験の「表層と構造」の関係に着目し、領域やメディアにとらわれず、分解と変換を用いた再構築を試みる。固定観念というレールから脱輪させ、見慣れてしまった表層世界に違和感を投げかける。

石北直之
総合診療医。2004年岩手医科大学医学部卒。臨床の最前線で最新医療でも解決できない課題に直面し、2023年に医療機器スタートアップ「STONY」を創業。神戸大学未来医工学研究開発センター客員准教授として後進の育成にも力を注ぐ。「目の前の患者を助けたい」という想いを原動力に、独創的なアイデアと技術力で、医療をシンプルにし患者と家族の人生を豊かにするソリューションを創造し続けている。*肩書きは2022年当時のもの。
#ワークショップ
科学、芸術、自然を体感するワークショップを開催します。
参加方法:要事前予約
千葉大学大学院園芸学研究院 応用昆虫学 野村昌史研究室《昆虫観察アウトドアワークショップ「科学と芸術の丘探検隊」》

photo: Yoshiaki Suzuki
日程:10/25(土)10:30~12:00 / 13:30~15:00
10/26(日)10:30~12:00 / 13:30~15:00
会場:戸定が丘歴史公園
料金:500円
定員:各回20名
対象:小学生以上 ※小学生低学年以下の方は保護者同伴
通路やお庭などを見て回り、戸定邸内の昆虫たちを探し出す探検隊を、今年も結成します。忙しく活動中の昆虫や冬越しの準備をしている虫たちを観察して、今の時期の昆虫たちの姿を浮かび上がらせます。季節を惜しむように活動する種類や、冬を乗り切る準備に忙しい姿を探しだします。身近な場所で小さな自然を一緒に観察しましょう!雨天決行です。
#トーク
科学、芸術、自然について考える対話を実践します。
会場:戸定邸、Youtubeでの同時配信あり
詳細は以下をご覧ください。
https://science-art-matsudo.net/program/talk
開催概要
科学と芸術の丘2025
会期:2025年10月24日(金)/ 25日(土)10:00 ~ 16:30 、26日(日)10:00 ~ 16:00
会場:千葉県松戸市(戸定邸、松雲亭、戸定が丘歴史公園、松戸市内各所)
料金:一般 1,000円、高校生・大学生 900円、松戸市市民割 500円(在住/在勤/在学の方)、中学生以下 無料
*チケットは9月下旬よりPeatixにて販売予定。
*当日は戸定邸入口前【総合受付】にて販売します(一般、高校生・大学生の当日券は+500円)。
*トーク・ワークショップ別途予約制、10/1(水)よりPeatixにて予約を開始します。
主催:松戸市、科学と芸術の丘実行委員会
企画運営:科学と芸術の丘実行委員会
※内容は予告なく変更する場合があります。
メディアの皆様向けプレスツアーを開催
出展アーティストへの直接のご取材も可能です。
日時:2025年10月23日(木) 14:00~15:30
会場:戸定邸・松雲亭・戸定が丘歴史公園
参加方法:【https://forms.gle/ad79ZrvuaGZSnCbS8】よりお申し込みください。
企業プレスリリース詳細へ
PR TIMESトップへ